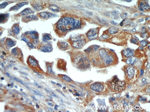
ACTN4 Antibody in Immunohistochemistry (Paraffin) (IHC (P))

Search
Proteintech
ACTN4 Polyclonal Antibody
{{$productOrderCtrl.translations['antibody.pdp.commerceCard.promotion.promotions']}}
{{$productOrderCtrl.translations['antibody.pdp.commerceCard.promotion.viewpromo']}}
{{$productOrderCtrl.translations['antibody.pdp.commerceCard.promotion.promocode']}}: {{promo.promoCode}} {{promo.promoTitle}} {{promo.promoDescription}}. {{$productOrderCtrl.translations['antibody.pdp.commerceCard.promotion.learnmore']}}
产品信息
19096-1-AP
种属反应
已发表种属
宿主/亚型
分类
类型
抗原
偶联物
形式
浓度
规格
纯化类型
保存液
内含物
保存条件
运输条件
产品详细信息
This antibody recognizes 100-105 kDa of endogenous ACTN4 protein in various lysates.
Immunogen sequence: TTVTPQIIN SKWEKVQQLV PKRDHALLEE QSKQQSNEHL RRQFASQANV VGPWIQTKME EIGRISIEMN GTLEDQLSHL KQYERSIVDY KPNLDLLEQQ HQLIQEALIF DNKHTNYTME HIRVGWEQLL TTIARTINEV ENQILTRDAK GISQEQMQEF RASFNHFDKD HGGALGPEEF KACLISLGYD VENDRQGEAE FNRIMSLVDP NHSGLVTFQA FIDFMSRETT DTDTADQVIA SFKVLAGDKN FITAEELRRE LPPDQAEYCI ARMAPYQGPD AVPGALDYKS FSTALYGESD L (612-911 aa encoded by BC005033)
靶标信息
Alpha actinins belong to the spectrin gene superfamily which represents a diverse group of cytoskeletal proteins, including the alpha and beta spectrins and dystrophins. Alpha actinin is an actin-binding protein with multiple roles in different cell types. In nonmuscle cells, the cytoskeletal isoform is found along microfilament bundles and adherens-type junctions, where it is involved in binding actin to the membrane. In contrast, skeletal, cardiac, and smooth muscle isoforms are localized to the Z-disc and analogous dense bodies, where they help anchor the myofibrillar actin filaments. This gene encodes a nonmuscle, alpha actinin isoform which is concentrated in the cytoplasm, and thought to be involved in metastatic processes. Mutations in this gene have been associated with focal and segmental glomerulosclerosis.
仅用于科研。不用于诊断过程。未经明确授权不得转售。
生物信息学
蛋白别名: actinin-Alpha-4; alpha actinin 4; Alpha-actinin-4; F-actin cross-linking protein; focal segmental glomerulosclerosis 1; Non-muscle alpha-actinin 4; transcriptional coactivator; unnamed protein product
基因别名: ACTININ-4; ACTN4; C77391; FSGS; FSGS1
UniProt ID: (Human) O43707, (Mouse) P57780, (Rat) Q9QXQ0
Entrez Gene ID: (Human) 81, (Mouse) 60595, (Rat) 63836